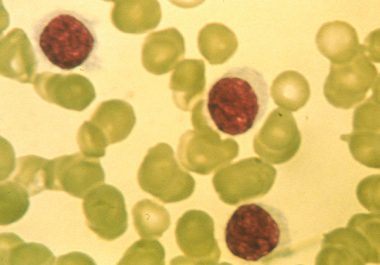

Targeting Chronic Lymphocytic Leukemia
Clinical trial results suggest patients with high-risk chronic lymphocytic leukemia may benefit from a combination of two targeted therapeutics. Patients with high-risk chronic lymphocytic leukemia (CLL) may benefit from a treatment regimen that combines...